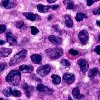

Запись
2720₽
+7+7 ( ..показать +7+7 (812) 507-54-54
Кдц Им. Г.и. Турнера На Лахтинской Улице Санкт-Петербург; ул. Лахтинская, д. 12, лит. А ; м. Чкаловская
Запись
2900₽
+7(800 ..показать +7(499) 11-68-239+7(800) 700-99-01 +7(863) 285-60-99 +7(928) 150-22-25
СигмаМед на Тельмана Ростов-на-Дону; ул. Тельмана, д. 110, стр. 1 ;
Запись
3200₽
+7(495 ..показать +7(499) 11-68-239+7(495) 796-54-08 +7(499) 164-96-24 +7(985) 229-29-90
Гален на Сиреневом бульваре Москва; Сиреневый б-р, д. 15 ; м. Щелковская
Запись
3600₽
+7(950 ..показать +7(499) 11-68-239+7(950) 024-66-92
МЦ ЛИЦ на Нарвском проспекте Санкт-Петербург; Нарвский пр-т, д. 18 ; м. Нарвская
Запись
3970₽
+7(800 ..показать +7(499) 11-68-239+7(800) 200-36-30 +7(495) 363-03-63
ИНВИТРО на Коломенской Москва; ул. Коломенская, д. 12, корп. 2 ; м. Коломенская
Запись
3970₽
+7(495 ..показать +7(499) 11-68-239+7(495) 363-03-63 +7(800) 200-36-30
ИНВИТРО на Зеленом проспекте Москва; Зеленый пр-т, д. 62, корп. 1 ; м. Новогиреево
Запись
3970₽
+7(495 ..показать +7(499) 11-68-239+7(495) 363-03-63 +7(800) 200-36-30
ИНВИТРО на Новоясеневском проспекте Москва; пр-т Новоясеневский, д. 9 ; м. Ясенево
Запись
3970₽
+7(495 ..показать +7(499) 11-68-239+7(495) 363-03-63 +7(800) 200-36-30
ИНВИТРО на Хорошевском шоссе Москва; Хорошевское шоссе, д. 22 ; м. Беговая
Запись
3970₽
+7(495 ..показать +7(499) 11-68-239+7(495) 363-03-63 +7(800) 200-36-30
ИНВИТРО в 1-м Кожуховском проезде Москва; 1-й Кожуховский проезд, д. 9 ; м. Автозаводская
Запись
4090₽
+7(863 ..показать +7(499) 11-68-239+7(863) 309-05-06
ЕвроДон на Вавилова Ростов-на-Дону; ул. Вавилова, д. 57 ;
Запись
4090₽
+7(863 ..показать +7(499) 11-68-239+7(863) 309-05-06
ЕвроДон на Социалистической Ростов-на-Дону; ул. Социалистическая, д. 208 ;
Запись
4400₽
+7(343 ..показать +7(499) 11-68-239+7(343) 305-25-26
Земская Больница на Таганской Екатеринбург; ул. Таганская, д. 79 ; м. Проспект Космонавтов
Запись
4400₽
+7(343 ..показать +7(499) 11-68-239+7(343) 272-33-32
Земская Больница на Готвальда Екатеринбург; ул. Готвальда, д. 14А ; м. Уральская
Запись
4400₽
+7(495 ..показать +7(499) 11-68-239+7(495) 660-38-55
Клиника Доктора Назимовой на проспекте Вернадского пр-т Вернадского; д. 127 ; м. Юго-Западная
Запись
4400₽
+7(343 ..показать +7(499) 11-68-239+7(343) 278-28-18
Земская Больница на Избирателей Екатеринбург; ул. Избирателей, д. 110 ; м. Проспект Космонавтов
Запись
4400₽
+7(495 ..показать +7(499) 11-68-239+7(495) 783-36-00 +7(800) 700-03-03
Хеликс на Коминтерна Москва; ул. Коминтерна, д. 15, корп. 1 ; м. Бабушкинская
Запись
4400₽
+7(495 ..показать +7(495) 126-17-27
Альфа-Центр Здоровья на Комсомольском проспекте Москва; Комсомольский пр-т, д. 17, стр. 11 ; м. Фрунзенская
Запись
4900₽
+7(495 ..показать +7(499) 11-68-239+7(495) 989-57-30
Олимп Клиник на Садовой-Сухаревской Москва; ул. Садовая-Сухаревская, д. 7/1 ; м. Цветной Бульвар
Запись
3970₽
+7(800 ..показать +7(499) 11-68-239+7(800) 200-36-30 +7(495) 363-03-63
Инвитро в Сосенском Новая Москва; пос. Сосенское, б-р Веласкеса, д. 2 ; м. Прокшино
Запись
3970₽
+7(800 ..показать +7(499) 11-68-239+7(800) 200-36-30 +7(495) 363-03-63
ИНВИТРО на Волгоградском проспекте Москва; Волгоградский пр-т, д. 51 ; м. Текстильщики
Ещё клиник - 146 . Используйте фильтры